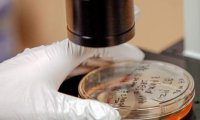
В России появится центр мониторинга биологических угроз

Суд продлил домашний арест Евгении Васильевой до 23 июня
Пресненский суд Москвы продлил на три месяца, до 23 июня, срок домашнего ареста бывшей главе департамента имущественных отношений Минобороны РФ Евгении Васильевой, обвиняемой в хищениях.

Пресненский суд Москвы продлил на три месяца, до 23 июня, срок домашнего ареста бывшей главе департамента имущественных отношений Минобороны РФ Евгении Васильевой, обвиняемой в хищениях.

Решение о продлении секторальных санкций ЕС, введенных в отношении России в июле прошлого года, скорее всего, будет приниматься на саммите глав государств Евросоюза в июне. На ближайшей встрече...

Согласно принятому в прошлом году законодательству, сведения о филиалах и представительствах иностранных компаний в РФ должны быть внесены в новый госреестр.

Пхеньян вновь продемонстрировал недовольство совместными маневрами США и Южной Кореи. Очередная демонстрация военной мощи состоялась в форме пуска семи ракет. Вероятно, за стрельбами лично наблюдал...
В России будет создан первый Национальный интеграционный центр мониторинга биологических угроз, который займется сбором и анализом информации об опасных вирусах, бактериях и возникающих эпидемиях на...

Консультации между ЕС и США об усилении санкционного давления на Россию продолжаются, однако конкретные меры и сроки их введения не оглашаются. Ограничения предполагается ввести в случае обострения...

Несмотря на поддержку Токио западных антироссийских санкций, пограничные ведомства двух стран продолжают тесно взаимодействовать. Летом нынешнего года у берегов Сахалина состоятся совместные маневры.

В ходе сегодняшнего заседания совет директоров Банка России принял решение снизить ключевую ставку с 15% до 14% годовых, поскольку баланс рисков по-прежнему смещен в сторону более значительного...

Следственный комитет России предъявил официальное обвинение в получении взятки в размере $5,6 млн губернатору Сахалинской области Александру Хорошавину. Его помощника обвинили в посредничестве при...

Представители пивоваренной отрасли в России говорят о множестве проблем, с которыми сталкиваются, причем они не только переживают падение продаж, но и вынуждены поднимать цены.

С таким заявлением в ходе VI Российского пенсионного конгресса выступил первый заместитель Банка России Сергей Швецов, назвавший такую возможность мифом.

Западные нефтегазовые концерны продолжают выходить из украинских проектов. О прекращении работ по разработке сланцевого газа в Харьковской области в четверг заявила Shell, мотивируя свое решение...

ФСБ прекратила уголовное преследование гражданки России, многодетной матери Светланы Давыдовой. Ранее ей вменялась государственная измена. Давыдова стала известна после звонка в посольство Украины с...

Исландия отзывает свою заявку на вступление в Евросоюз и не будет возобновлять переговоры, начатые четыре года назад предыдущим правительством, заявил накануне глава МИД страны Гуннар Браги Свейнссон...

Индивидуальная гонка на 20 км у мужчин на чемпионате мира по биатлону в Контиолахти в отличие от женской «индивидуалки» обошлась без сюрпризов. Записные фавориты не подпустили близко к пьедесталу...

Глава Сбербанка Герман Греф и его партнер, многопрофильный предприниматель Юрий Жуков нашли свой выход из кризиса – в кэш и за бугор. «Друг Грефа пачками скупает уральские заводы», - пишут уральские...

ОБСЕ продлила мандат миссии на Украине до 31 марта 2016 года. Такое решение принял сегодня постоянный совет Организации. В документе отмечается, что при необходимости миссия может быть расширена до...

Количество погибших от вспышки лихорадки Эбола, начавшейся в прошлом году в Западной Африке, превысило 10 тысяч человек. Об этом в четверг, 12 марта, сообщили во Всемирной организации здравоохранения...

Петербургский "Зенит" и московское "Динамо" провели первые матчи 1/8 финала Лиги Европы УЕФА. "Зенит" на своем поле одержал победу над итальянским "Торино", а клуб из Москвы, встречаясь с другой...

Огромный провокационный рекламный щит с полуобнаженной монахиней вывешен на предполагаемом маршруте следования кортежа Папы Франциска в Неаполе, Италия.